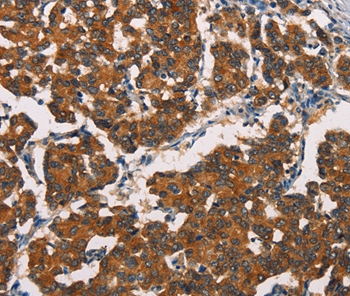
Anti-ASIC1 Antibody

ASIC1 Antibody (OASE00275)
OASE00275
ApplicationsImmunoFluorescence, Western Blot, ImmunoCytoChemistry, ImmunoHistoChemistry
Product group Antibodies
TargetAsic1
Overview
- SupplierAviva Systems Biology
- Product NameASIC1 Antibody (OASE00275)
- Delivery Days Customer23
- ApplicationsImmunoFluorescence, Western Blot, ImmunoCytoChemistry, ImmunoHistoChemistry
- CertificationResearch Use Only
- ClonalityMonoclonal
- Clone IDS271-44
- Concentration1 mg/ml
- ConjugateUnconjugated
- Gene ID11419
- Target nameAsic1
- Target descriptionacid-sensing ion channel 1
- Target synonymsASIC, ASIC1a, ASIC1b, Accn2, B530003N02Rik, BNaC2, acid-sensing ion channel 1, acid-sensing (proton-gated) ion channel 1, amiloride-sensitive cation channel 2, neuronal, brain sodium channel 2, degenerin 2
- HostMouse
- IsotypeIgG1
- Scientific DescriptionAcid sensing ion channel ASIC1, also designated ACCN2, BNAC2 and ASIC1a, is present in brain as a 4.3-kb transcript with localization to rat dorsal root ganglia. Insitu hybridization of rat brain suggests that ASIC1 is most abundant in the main olfactory bulb, cerebral cortex, hippocampal formation, habenula, basolateral amygdaloid nuclei and cerebellum. ASIC1 and H+-gated currents may contribute to the development of fear and anxiety.
- Storage Instruction-20°C
- UNSPSC12352203